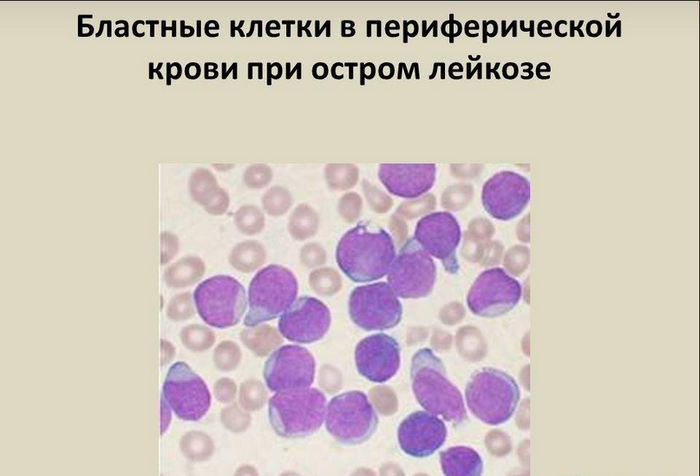
«Силы уходят!» Случай из практики

Жгут на шею
Я не должен был ехать на тот вызов. Была очередь другого врача, но он куда-то вышел со станции, а мобильных телефонов в то время не было. Вот диспетчер и отдала этот вызов мне: «Съезди, посмотри. Там, скорее всего, остеохондроз. 30-летний мужчина, боль в шее, и невозможность повернуть голову».
И я поехал на вызов в расположенное неподалёку общежитие для сотрудников Метростроя.
-Вы один, доктор?» - спросила меня пожилая вахтёрша. Они ведь там все пьяные.
- Вот чудеса-то, - ответил я. Новогодний вечер, рабочее общежитие. Откуда там пьяным взяться? Не может такого быть.
- Вы всё-таки осторожнее, - улыбнулась она, - Звуки оттуда доносятся какие-то совсем нехорошие.
Я поднялся по лестнице, и вошёл в комнату. Прямо напротив входа лежал опрокинутый стол, валялись осколки посуды и бутылок. Вся комната была забрызгана кровью. Кровь была на мебели и стенах. Кровью была забрызганы двери и окна. Складывалось впечатление, что совсем недавно в этой комнате произошла драка с применением холодного оружия, большинство участников которой, получив ранения, покинули помещение,. Оставался только один человек, который, слегка постанывая, лежал на полу. Подойдя к нему, я увидел, что на левой стороне шеи у него располагается бордово-красное пульсирующее образование, из небольшой дырочки в котором вытекает кровь. По-видимому, рана была нанесена шилом. Колотая рана шеи, возможно, ранение сонной артерии! Это жизнеугрожающее состояние, требующее срочной остановки кровотечения и госпитализации. При беглом осмотре других травм обнаружено не было.
Я не побежал в машину за шиной Крамера, которую обычно используют для наложения жгута на шею (это показано на правой картинке). Время терять было нельзя. Подняв правую руку пациента, я наложил жгут, и побежал искать его соседей, чтобы они помогли нести. Откликнулись многие, и, положив пострадавшего на грязное, замазанное кровью покрывало, быстро доставили его в машину. Я сильно рисковал, доверив пьяным нести такого пациента. Если бы они его уронили, диагноз мог быть расширен, но, к счастью, всё обошлось. До больницы долетели за несколько минут и, сдав пациента хирургам, не спеша поехали на станцию. До Нового 1996 года оставалось часа полтора.
Сидя в кабине, я заполнял историю болезни, и вдруг водитель спросил – «Останавливаемся или дальше поедем?» Оторвавшись от истории, я увидел человека в потёртой коричневой шубе, лежащего прямо в сугробе на обочине дороги. Шуба мне показалась знакомой… «Конечно, останавливаемся – замёрзнет же!» - ответил я. Мы вышли из машины, вытащили человека из сугроба, и не поверили глазам – это был тот самый врач, из-за которого мы вне очереди поехали на вызов. Рядом лежала литровая бутылка водки, опустошённая примерно наполовину. Мы привезли его на станцию (не госпитализировать же его с алкогольным отравлением), где он благополучно проспал до самого утра. Позже он рассказал мне, что пошёл подышать свежим воздухом на улицу, потом купил водку в ближайшем ларьке – надо ведь отметить Новый год, отхлебнул из горлышка. Что было потом, помнит смутно.
Вообще, тот вечер, 31 декабря 1995 года был богат на события. Следующий вызов (а я успел его сделать до наступления Нового года) был ещё более необычным…